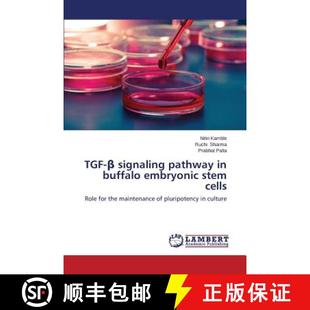

and Related TGF Cytokines Inflammation 预订
¥548满500减50售0件

Signaling Beta TGF 9781071622766 预订
¥2190满1999减200售0件

Tino Que Tgf Acide Beta 预售
¥1117满999减100售0件

Signaling 预订 TGF
¥1259满999减100售0件

Tgf and Beta Methods Protocols Signaling 预订
¥1424满999减100售0件

and Related TGF Cytokines Inflammation 预售
¥1450满999减100售0件

预订 Human TGF Disease
¥1643满999减100售0件

预订 Human TGF Disease
¥1643满999减100售0件

TGF Signaling 预订
¥1753满999减100售0件

Related Cytokines 海外直订医药图书TGF TGF and Inflammation B与炎症相关细胞因子
¥795满600减30售0件

及信号 Signaling 海外直订TGF Beta
¥1128满600减30售0件

946; Human Disease 946;人类疾病 海外直订Tgf Tgf
¥1538满600减30售0件

Human Disease 海外直订Tgf β在人类疾病中 946; Tgf 作用
¥1551满600减30售0件

Inflammation 相关细胞因子 And 946;炎症中 Tgf Cytokines Related 海外直订医药图书Tgf
¥553满300减5售0件
buffalo TGF pathway 预订 embryonic 9783659555756 946; cells signaling stem
¥587587售0件

TGF& 9783659689901 Risk Polymorphism Factor gene 946;1 Preeclampsia 预订 for
¥755755售0件

Signaling 9781493949939 4周达 Protocols and Methods 946; Tgf
¥13271327售0件

TGF Beta Protocols 9781071622797 and 4周达 Methods Signaling
¥14341434售0件

946;1 预订 Genomic levels ESRD Protein TGF and mRNA 9783659616365 Investigations
¥10891089售0件

Related 9783764360092 3周达 Inflammation Cytokines and TGF
¥12821282售0件

9783034895316 Tgf And Related 946; 4周达 Inflammation Cytokines
¥598598售0件

Factor 9783659781445 946;1 Transforming Growth Beta Tumors 预订 TGF Solid
¥698698售0件

Expression Study and 预订 9786202013710 TGF Cancer Thyroid EGFR
¥798798售0件

Tgf Disease 9784431546863 Human 4周达 946;
¥16981698售0件

TGF Beta Protocols 9781071622766 and 4周达 Methods Signaling
¥22982298售0件

Tgf Disease 9784431544081 Human 4周达 946;
¥17521752售0件

Signaling 9781493929658 4周达 Protocols and Methods 946; Tgf
¥18791879售0件